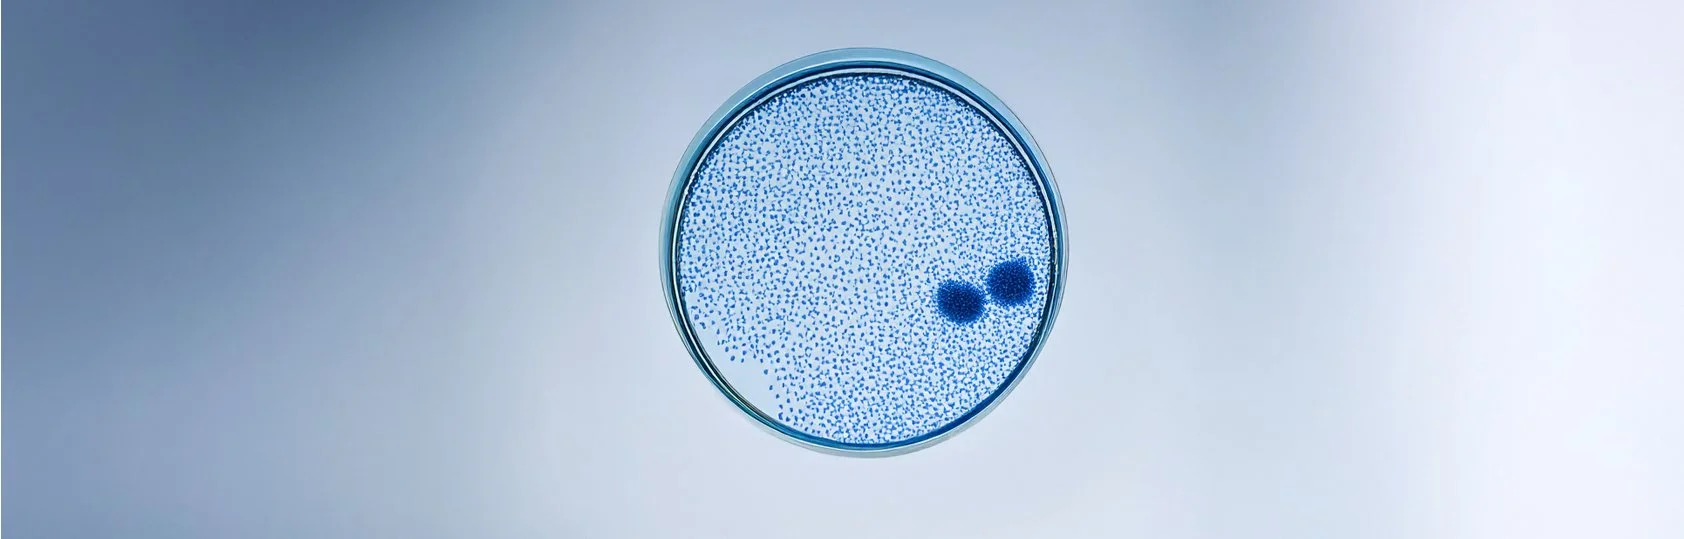

Founded in 2011 in London, now based in Berlin, our brand emerged from a bold idea: to rethink the way we approach clothing by reconnecting it to the human form.
At the core of our concept lies the human skeleton – a structure that is at the very foundation of who we are, but also connects us all, as the one aspect we all share as human beings. It transcends cultural constructs like gender or race. Our designs explore the natural relationship between the body and the clothing that covers it, grouping garments into categories, in correlation to the bones they cover, and by naming those after this specific bone, we want to change the narrative, how we address clothing and by this, taking them to a neutral state, free from gender normative terminology. This approach allows us to break down traditional barriers and embrace a non-gendered perspective, where clothing no longer has to adhere to outdated norms.
Our commitment to sustainability is woven into the fabric of our brand. We work exclusively with deadstock and upcycled fabrics and materials, ensuring that every piece has a minimal environmental footprint. Each item is made to order, crafted locally with precision and attention to detail, often tailored to the individual’s measurements for the perfect fit. In a globally connected world where seasons feel increasingly irrelevant, our collections transcend time. We offer both timeless, base capsule wardrobe pieces and exclusive special collections, all created without the constraints of traditional fashion cycles.
We are more than just a fashion brand; we are advocates for a non-gendered future of fashion, we are questioning existing constructs and dissolving the social norms that limit self-expression. Our mission is to redefine fashion and pave the way to a truly inclusive future of the industry.
FOLLOW US ON SOCIAL



